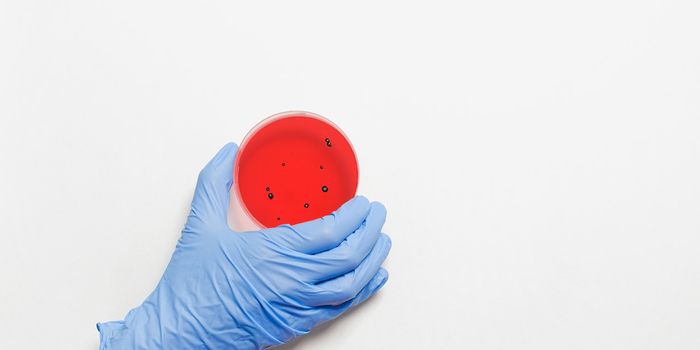
AI Platform Finds Superbugs Faster

Method optimization
In medical research, method optimization evaluates ways to minimize or maximize specific parameters of a study. Optimization can involve parameters such as reducing the costs associated with a procedure, limiting the materials required to develop an assay, or obtaining maximal productivity from a technique.
-
JUN 02, 2022CancerClinical Trials represent an integral component of biomedical research. These research studies utilize human subje ...Written By: Katie KokolusMAY 09, 2022Clinical & Molecular DXThe heart is made up in part of cardiomyocytes, specialized cells responsible for controlling heart beats. After a heart ...Written By: Zoe MichaudMAY 09, 2022CancerFollowing a successful course of cancer treatment, a patient may enter remission. Remission, classified as either partia ...Written By: Katie KokolusMAY 06, 2022Drug Discovery & DevelopmentModern medicine has drastically changed since humans discovered the first ancient treatment methods. Herbal remedies and ...Written By: Mandy WoodsAPR 09, 2022Cannabis SciencesLabroots hosted its 5th annual Cannabis Science Virtual Event on March 23, 2022. The speaker roster for this free confer ...Written By: Kerry CharronAPR 01, 2022Drug Discovery & DevelopmentCannabigerol (CBG) has significant potential to treat neurological disorders according to a recent study published in Ph ...Written By: Kerry CharronMAR 15, 2022Clinical & Molecular DXThere are many challenges facing our healthcare system today, but sepsis is undeniably one of the most significant. Seps ...Sponsored By: bioMérieux IncMAR 15, 2022Clinical & Molecular DXAccording to Alzheimer's Association, one in nine people over 65 are currently living with Alzheimer's dise ...Written By: Katie KokolusMAR 02, 2022Plants & AnimalsWho doesn’t love chocolate? There’s plenty to like about! Maybe that’s why it’s estimated that t ...Written By: Ryan VingumFEB 11, 2022Cannabis SciencesAccording to a recent study published in Oncotarget, cannabis extracts may harbor the potential to eventually be tailore ...Written By: Nadine HusamiFEB 03, 2022Space & AstronomyGetting to Mars is hard. Really hard. Really, really hard. It’s so unbelievably hard, it takes years—often d ...Written By: Laurence Tognetti, MScJAN 25, 2022Clinical & Molecular DXIn 1945, Sir Alexander Fleming (the microbiologist who discovered the world's first broadly effective antibio ...Written By: Tara FernandesDEC 15, 2021Genetics & GenomicsCRISPR gene editing tools have become common in biomedical research, and scientists have been able to apply this technol ...Written By: Carmen LeitchDEC 12, 2021Drug Discovery & DevelopmentWith gene therapy demonstrating an enormous potential to treat a wide range of diseases, Cyagen has added a range of gen ...DEC 11, 2021TechnologySepsis is a life-threatening condition that takes the lives of almost a quarter of a million people each year. Able to p ...Written By: Ryan VingumDEC 03, 2021Earth & The EnvironmentFolks have different opinions about what constitutes a healthy diet, and what constitutes an environmentally friendly di ...Written By: Samantha LottNOV 22, 2021Health & MedicineIn therapeutic applications, monoclonal antibodies (mAbs) provide highly precise targeting of pathological cells and red ...NOV 10, 2021Cannabis SciencesHemp cultivation is propelling to the forefront of the agricultural industry. Harvested primarily for fiber and seeds, i ...Written By: Nadine HusamiNOV 08, 2021Clinical & Molecular DXAs scientists, we can be very uncomfortable with the concept of “good enough”. It feels contrary to everythi ...NOV 03, 2021Health & MedicineThe wonders of sleep. What a good night's sleep can do for our resistance to stress, memory, and creative insight. S ...Written By: Alexandria BassOCT 28, 2021Health & MedicineA common problem in wound care is determining what’s below the surface of the bandage. Once a dressing is applied, ...Written By: Hannah DanielOCT 08, 2021Cannabis SciencesAs medical cannabis becomes legalized around the globe, patients need to explore which routes of cannabis delivery best ...Written By: Kerry CharronSEP 22, 2021CancerThe human genome consists of genetic material known as DNA. We all have unique DNA sequences made up of four bases ...Written By: Katie KokolusSEP 15, 2021Plants & AnimalsBack in 2010, the U.S. Department of Agriculture (USDA) estimated that nearly 133 billion pounds of food went to waste, ...Written By: Ryan Vingum
JUN 02, 2022
Cancer
Clinical Trials represent an integral component of biomedical research. These research studies utilize human subje
...
Written By:
Katie Kokolus
MAY 09, 2022
Clinical & Molecular DX
The heart is made up in part of cardiomyocytes, specialized cells responsible for controlling heart beats. After a heart
...
Written By:
Zoe Michaud
MAY 09, 2022
Cancer
Following a successful course of cancer treatment, a patient may enter remission. Remission, classified as either partia
...
Written By:
Katie Kokolus
MAY 06, 2022
Drug Discovery & Development
Modern medicine has drastically changed since humans discovered the first ancient treatment methods. Herbal remedies and
...
Written By:
Mandy Woods
APR 09, 2022
Cannabis Sciences
Labroots hosted its 5th annual Cannabis Science Virtual Event on March 23, 2022. The speaker roster for this free confer
...
Written By:
Kerry Charron
APR 01, 2022
Drug Discovery & Development
Cannabigerol (CBG) has significant potential to treat neurological disorders according to a recent study published in Ph
...
Written By:
Kerry Charron
MAR 15, 2022
Clinical & Molecular DX
There are many challenges facing our healthcare system today, but sepsis is undeniably one of the most significant. Seps
...
Sponsored By:
bioMérieux Inc
MAR 15, 2022
Clinical & Molecular DX
According to Alzheimer's Association, one in nine people over 65 are currently living with Alzheimer's dise
...
Written By:
Katie Kokolus
MAR 02, 2022
Plants & Animals
Who doesn’t love chocolate? There’s plenty to like about! Maybe that’s why it’s estimated that t
...
Written By:
Ryan Vingum
FEB 11, 2022
Cannabis Sciences
According to a recent study published in Oncotarget, cannabis extracts may harbor the potential to eventually be tailore
...
Written By:
Nadine Husami
FEB 03, 2022
Space & Astronomy
Getting to Mars is hard. Really hard. Really, really hard. It’s so unbelievably hard, it takes years—often d
...
Written By:
Laurence Tognetti, MSc
JAN 25, 2022
Clinical & Molecular DX
In 1945, Sir Alexander Fleming (the microbiologist who discovered the world's first broadly effective antibio
...
Written By:
Tara Fernandes
DEC 15, 2021
Genetics & Genomics
CRISPR gene editing tools have become common in biomedical research, and scientists have been able to apply this technol
...
Written By:
Carmen Leitch
DEC 12, 2021
Drug Discovery & Development
With gene therapy demonstrating an enormous potential to treat a wide range of diseases, Cyagen has added a range of gen
...
DEC 11, 2021
Technology
Sepsis is a life-threatening condition that takes the lives of almost a quarter of a million people each year. Able to p
...
Written By:
Ryan Vingum
DEC 03, 2021
Earth & The Environment
Folks have different opinions about what constitutes a healthy diet, and what constitutes an environmentally friendly di
...
Written By:
Samantha Lott
NOV 22, 2021
Health & Medicine
In therapeutic applications, monoclonal antibodies (mAbs) provide highly precise targeting of pathological cells and red
...
NOV 10, 2021
Cannabis Sciences
Hemp cultivation is propelling to the forefront of the agricultural industry. Harvested primarily for fiber and seeds, i
...
Written By:
Nadine Husami
NOV 08, 2021
Clinical & Molecular DX
As scientists, we can be very uncomfortable with the concept of “good enough”. It feels contrary to everythi
...
NOV 03, 2021
Health & Medicine
The wonders of sleep. What a good night's sleep can do for our resistance to stress, memory, and creative insight. S
...
Written By:
Alexandria Bass
OCT 28, 2021
Health & Medicine
A common problem in wound care is determining what’s below the surface of the bandage. Once a dressing is applied,
...
Written By:
Hannah Daniel
OCT 08, 2021
Cannabis Sciences
As medical cannabis becomes legalized around the globe, patients need to explore which routes of cannabis delivery best
...
Written By:
Kerry Charron
SEP 22, 2021
Cancer
The human genome consists of genetic material known as DNA. We all have unique DNA sequences made up of four bases
...
Written By:
Katie Kokolus
SEP 15, 2021
Plants & Animals
Back in 2010, the U.S. Department of Agriculture (USDA) estimated that nearly 133 billion pounds of food went to waste,
...
Written By:
Ryan Vingum